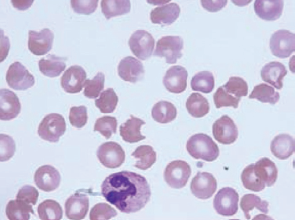
blood

Consultations & Comments: December 2013
Your colleagues posted these comments about content published in Consultant for Pediatricians and at www.PediatricsConsultant360.com. To add your voice to the conversation, login at the site and use the “add new comment” feature at the bottom of each article, or send your comments in a email to Editor@PediatricsConsultant360.com.
In response to September’s Photoclinic article on infantile pyknocytosis, by Bhavana Kandikattu, MD, and Jiyeon Kim, MD:
Very nice presentation and memory refresher. I just wondered about the normal reticulocyte count in a patient with acute hemolysis. Any explanation? Thanks. —Rafael Cheas, MD
The author responds:
Dr Cheas asks a great question. Looking through the patient’s chart again, it appears that this reticulocyte count was done at the time of admission. Since the measurement was taken during the acute hemolytic phase, the bone marrow may not yet have caught up with making more reticulocytes.
A reticulocyte count was not done in the next few days, but had it been done, it could have demonstrated an increased number of reticulocytes. The smear was classic for pyknocytes, and that clinched the diagnosis at that time. —Bhavana Kandikattu, MD
In response to “Negative Adult Outcomes Prompt Expert to Urge Taking Pediatric ADHD Seriously,” part of Consultant for Pediatricians’ online coverage of the American Academy of Pediatrics National Conference and Exhibition in late October:
As a pediatrician whose brother with ADHD died from suicide, and a mother of a young adult with ADHD who also was suicidal for a year and is still on medications, I couldn’t agree more.
This is a serious problem, and my daughter, now in college, has been told by peers that her ADHD medications are giving her an unfair advantage at school, and she has considered stopping them.
—pediatrician mom
In response to a What’s Your Diagnosis? article on a case of roseola infantum, by Alexander K. C. Leung, MD, from the Consultant for Pediatricians archive:
Very good review of HHV-6 (human herpesvirus 6) roseola infantum. I was unaware that HHV-7 was also a source. Thank you. —Baltazar R. Ramos, MD
In response to a recent blog post from Consultant for Pediatricians blogger Roy Benaroch, MD, “Should We Check Blood Pressures Routinely in Children?”:
I agree wholeheartedly with you. And as far as time, I do three at each annual examination—lying down and in both arms. If a discrepancy is found of more than 10 mm Hg, I recheck, because this can show a possible cardiac problem. It takes less than 2 minutes, and I feel more confident about my total exam.
—Ronald Dreyer, MD
In response to July’s Photoclinic article on a case of Mycoplasma pneumoniae and concomitant Kawasaki disease, by Nitin Chanana, MD, and Peter Noronha, MD:
This child has Kawasaki disease, so he needs to be followed appropriately with timely echocardiograms and needs to continue aspirin therapy for no less than 6 weeks post-disease.
I am never comfortable with the diagnosis of Mycoplasma pneumoniae infection based just on serology. I have seen a large number of patients whose IgM titers remain positive for a long time. As an infectious disease specialist, I get frequent referrals for recurrent Mycoplasma infection. These diagnoses are based on serology, and I when I repeat the IgM months after the infection, the patient is still IgM-positive.
Ever since we adopted the use of PCR for the diagnosis of Mycoplasma respiratory infections, the number of cases has declined. —Marcelo Laufer, MD
In response to July’s Photoclinic article on a case of bilateral ocular eczema herpeticum, by Charles L. Clark III, MD; Robert J. Applebaum, BS; Nausheen Khuddus, MD; Sanjeev Tuli, MD; and Sonal Tuli, MD:
I find this case to be especially concerning, because this 9½-year-old child was infected with herpes simplex virus on his lips, eyes, left side of neck, and penis. It seems that someone was, at the least, very inappropriately kissing this child, and I hope the authors addressed the potential child abuse aspect, as well as the medical aspects of this case.
I am disappointed that they did not bring out the ‘infections presenting on the face may also lead to a bigger-picture issue’ side of this story. Thank you for the article. —Susan, PNP, PhD
